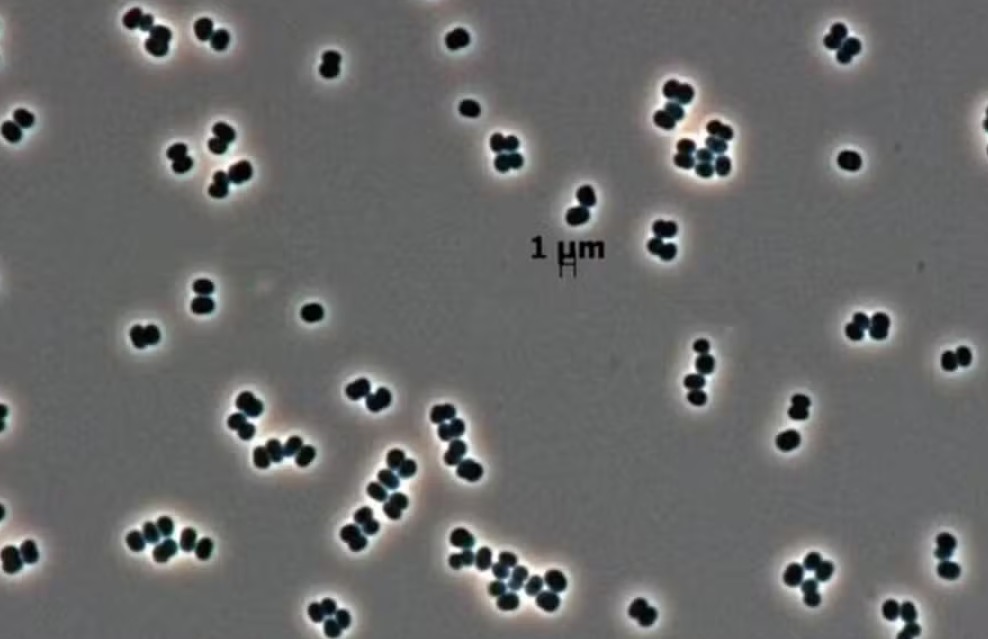
Bactéria 'se faz de morta' e pode ter chegado a Marte em naves da Nasa

Cotação Micro GPT (MICRO)
O preço ao vivo de Micro GPT (MICRO) hoje é $ 0.000214, com uma variação de 3.88% nas últimas 24 horas. A taxa de conversão atual de MICRO para USD é de $ 0.000214 por MICRO.
Micro GPT ocupa atualmente a posição #2903 em capitalização de mercado, totalizando $ 160.39K, com um fornecimento em circulação de 749.49M MICRO. Nas últimas 24 horas, MICRO foi negociado entre $ 0.000206 (mínimo) e $ 0.000214 (máximo), refletindo uma atividade de mercado. Sua máxima histórica é de $ 0.055855382276555225, enquanto a mínima histórica foi de $ 0.000164977224472432.
No desempenho de curto prazo, MICRO movimentou-se 0.00% na última hora e +7.53% nos últimos 7 dias. No último dia, o volume total de negociação atingiu $ 178.97.
No.2903
74.94%
ETH
A capitalização de mercado atual de Micro GPT é $ 160.39K, com um volume de negociação de 24 horas de $ 178.97. A oferta em circulação de MICRO é 749.49M, com um fornecimento total de 1000000000. Sua avaliação totalmente diluída (FDV) é de $ 214.00K.
0.00%
+3.88%
+7.53%
+7.53%
Acompanhe as variações de preço de Micro GPT para hoje, 30 dias, 60 dias e 90 dias:
| Período | Variação (USD) | Variação (%) |
|---|---|---|
| Hoje | $ +0.00000799 | +3.88% |
| 30 dias | $ -0.000023 | -9.71% |
| 60 dias | $ -0.000278 | -56.51% |
| 90 dias | $ -0.000709 | -76.82% |
Hoje, MICRO registrou uma variação de $ +0.00000799 (+3.88%), refletindo sua atividade mais recente no mercado.
Nos últimos 30 dias, o preço variou em $ -0.000023 (-9.71%), refletindo o desempenho de curto prazo do token.
Expandindo a visualização para 60 dias, MICRO teve uma variação de $ -0.000278 (-56.51%), oferecendo uma perspectiva mais ampla sobre seu desempenho.
Analisando a tendência de 90 dias, o preço variou em $ -0.000709 (-76.82%), oferecendo uma visão sobre a trajetória de longo prazo do token.
Confira agora toda a história de preços e os movimentos de Micro GPT (MICRO)!
Confira agora a página de histórico de preço do Micro GPT.
Em 2040, o preço de Micro GPT pode potencialmente apresentar um crescimento de 0.00%. Ele pode atingir um preço de negociação de $ --.
Pronto para começar com Micro GPT? Comprar MICRO é rápido e fácil para iniciantes na MEXC. Você pode começar a negociar instantaneamente assim que fizer sua primeira compra. Para saber mais, confira nosso guia completo sobre como comprar Micro GPT. Abaixo está um rápido passo a passo em 5 etapas para ajudar você a iniciar sua jornada de compra de Micro GPT (MICRO).

Possuir Micro GPT permite que você vá além de simplesmente comprar e fazer hold. Você pode negociar BTC em centenas de mercados, ganhar recompensas passivas por meio de produtos de staking e poupança flexíveis ou usar ferramentas de negociação profissionais para aumentar seus ativos. Seja você um iniciante ou um investidor experiente, a MEXC torna fácil maximizar seu potencial no mundo cripto. Abaixo estão as quatro principais maneiras de aproveitar ao máximo seus tokens de Bitcoin.
Comprar Micro GPT (MICRO) na MEXC significa mais valor para o seu dinheiro. Como uma das plataformas cripto com as taxas mais baixas do mercado, a MEXC ajuda você a reduzir custos desde a sua primeira negociação.
Confira as taxas de negociação competitivas da MEXC
Além disso, você pode negociar tokens spot selecionados sem nenhuma taxa por meio da Festa da taxa zero da MEXC.
MicroGPT is an advanced AI platform designed to streamline and democratize software development for developers of all levels. Offering real-time coding suggestions, IDE integration, and a unique "Code to Earn" rewards system, MicroGPT empowers users to code efficiently and collaboratively across mobile, web, and desktop. With an emphasis on accessibility and productivity,
Para uma compreensão mais aprofundada de Micro GPT, considere explorar recursos adicionais, como o whitepaper, o site oficial e outras publicações:
| Hora (UTC+8) | Tipo | Informação |
|---|---|---|
| 12-10 15:28:09 | Atualizações da Indústria | Índice de medo cripto sobe para 22, mercado permanece em estado de "medo extremo" |
| 12-09 18:21:38 | Política Monetária | Hong Kong lança consulta pública sobre a implementação do quadro de relatórios de ativos cripto e alterações ao padrão comum de comunicação |
| 12-09 16:43:33 | Atualizações da Indústria | Os ETFs spot de Bitcoin registaram saídas líquidas de $60,40 milhões ontem, enquanto os ETFs de Ethereum registaram entradas líquidas de $35,50 milhões |
| 12-09 05:21:05 | Atualizações da Indústria | Taxas totais diárias de pagamento na rede Ethereum atingem o nível mais baixo desde julho de 2017 |
| 12-08 23:34:37 | Atualizações da Indústria | Os produtos de investimento em ativos digitais registaram entradas líquidas de 716 milhões de dólares na semana passada |
| 12-08 21:19:13 | Atualizações da Indústria | Entradas divergentes nos fundos ETF de criptomoedas na última sexta-feira: Criptomoedas populares sob pressão, produtos alternativos atraem capital contra a tendência |

Explore o mercado Spot e Futuros, confira o preço ao vivo, volume de negociação e negocie diretamente o Micro GPT.
Principais criptomoedas com dados de mercado disponíveis na MEXC
Os preços de criptomoedas estão sujeitos a altos riscos de mercado e volatilidade de preços. Deve-se investir em projetos e produtos com os quais está familiarizado e onde entende os riscos envolvidos. Deve-se considerar cuidadosamente a sua experiência de investimento, situação financeira, objetivos de investimento e tolerância ao risco e consultar um assessor financeiro independente antes de fazer qualquer investimento. Este material não deve ser interpretado como aconselhamento financeiro. O desempenho passado não é um indicador confiável do desempenho futuro. O valor do seu investimento pode ir tanto para baixo quanto para cima, e talvez não recupere o montante investido. Você é o único responsável por suas decisões de investimento. A MEXC não se responsabiliza por quaisquer perdas que possa incorrer. Para maiores informações, consulte os nossos Termos de Uso e Aviso de Risco. Observe também que os dados relativos à criptomoedas acima mencionada aqui apresentados (como o seu preço atual ao vivo) são baseados em fontes de terceiros. Elas são apresentadas a você "como estão" e somente para fins informativos, sem representação ou garantia de qualquer tipo. Os links fornecidos para sites de terceiros também não estão sob o controle da MEXC. A MEXC não é responsável pela confiabilidade e precisão de tais sites de terceiros e o seu conteúdo.
Montante
1 MICRO = 0.000214 USD